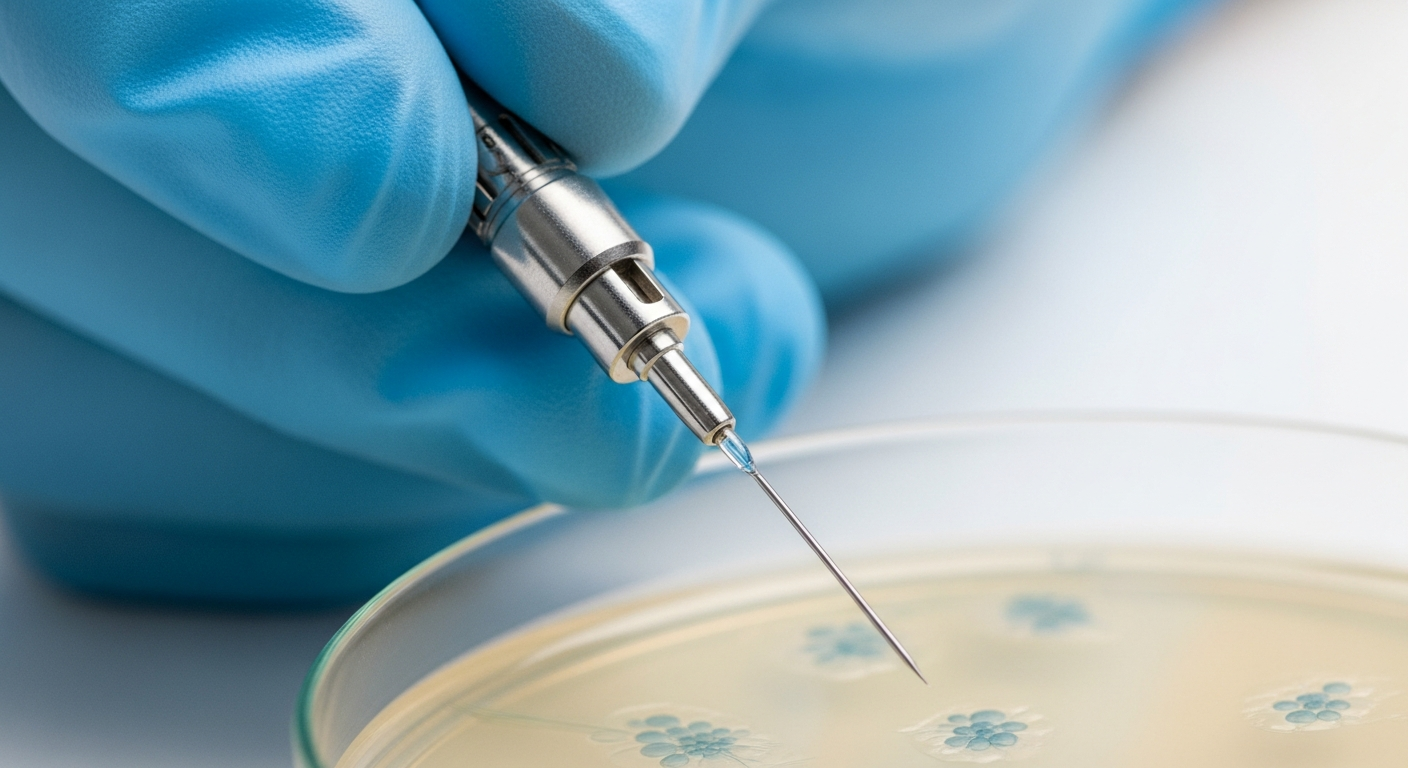

Des scientifiques pensent avoir résolu l’un des principaux défis de la fécondation in vitro
Auteur: Simon Kabbaj
Un nouvel espoir pour la fertilité tardive ?

C’est une nouvelle qui pourrait bien faire l’effet d’une bombe dans le monde souvent éprouvant de la procréation médicalement assistée. Vous le savez peut-être, ou vous l’avez vécu, la fécondation in vitro (FIV) est souvent un parcours du combattant, surtout lorsque les années passent. Mais voilà que des scientifiques pensent avoir trouvé une faille dans ce mur biologique qui semblait infranchissable. Dans une étude préliminaire publiée ce mois-ci, plus précisément autour du 12 janvier 2026, une équipe de chercheurs affirme avoir réussi à inverser un défaut lié à l’âge qui affecte les ovules.
Ce défaut, c’est celui qui rend les ovules « vieux » et qui entraîne un nombre anormal de chromosomes, causant la majorité des échecs de FIV chez les femmes plus âgées. L’idée est séduisante, n’est-ce pas ? Si ces résultats sont validés, cela pourrait prolonger la période durant laquelle la FIV reste une option viable pour les familles. Comme l’a confié Melina Schuh, directrice à l‘Institut Max Planck de sciences multidisciplinaires à Göttingen, au journal The Guardian la semaine dernière : « Ce qui est vraiment beau, c’est que nous avons identifié une protéine unique qui, avec l’âge, diminue, nous l’avons ramenée aux niveaux de la jeunesse et cela a un effet important ». Une simple protéine… parfois, la nature tient à peu de choses.
Au cœur du problème : La valse des chromosomes

Pour bien comprendre, il faut se pencher un instant sur ce qui se passe à l’échelle microscopique. Un embryon viable, c’est une mathématique précise : il doit contenir 46 chromosomes. C’est la base. 23 sont fournis par le spermatozoïde, et 23 par l’ovule. Mais pour arriver à ce chiffre parfait, ces cellules sexuelles doivent d’abord se diviser et perdre la moitié des chromosomes que l’on trouve habituellement dans une cellule humaine. Ce processus, un peu complexe, s’appelle la méiose.
Le problème, c’est que la mécanique se grippe parfois. Un certain pourcentage d’ovules humains aura, sans aucun doute, le mauvais nombre de chromosomes après cette division. C’est ce qu’on appelle l’aneuploïdie. Ce phénomène, malheureusement, devient beaucoup plus fréquent à mesure que les femmes vieillissent. C’est d’ailleurs la raison majeure pour laquelle la FIV a beaucoup moins de chances de fonctionner avec des ovules prélevés sur des femmes de plus de 40 ans. Cette aneuploïdie liée à l’âge est principalement causée par une séparation mal synchronisée des paires de chromosomes identiques pendant la méiose.
C’est ici que les travaux précédents de Melina Schuh et de son équipe entrent en scène. Ils ont suggéré qu’une protéine bien spécifique, la Shugoshin 1 (SGO1), est cruciale pour empêcher cette erreur. Et devinez quoi ? Ils ont montré que les niveaux de cette protéine ont tendance à chuter drastiquement dans les ovules plus âgés. C’est un peu comme si la colle qui tenait tout ensemble séchait avec le temps.
L’expérience : Une injection de jouvence cellulaire
Alors, qu’ont-ils fait ? Dans cette nouvelle étude, ils ne se sont pas contentés d’observer. Ils ont agi. Ils ont effectué des micro-injections de Shugoshin 1 dans des ovules de souris et des ovules humains – ces derniers ayant été généreusement donnés par des patientes d’une clinique de fertilité. Les résultats sont pour le moins intrigants. Dans les deux groupes, l’ajout de la protéine a semblé augmenter ses niveaux à l’intérieur des ovules et, surtout, réduire le risque de séparation incorrecte des chromosomes.
Les chiffres parlent d’eux-mêmes, et ils sont assez frappants. Plus de la moitié des ovules humains sans traitement présentaient ce défaut chromosomique. En revanche, ce chiffre tombait à seulement 29 % pour les ovules ayant reçu le supplément de Shugoshin 1. C’est une différence massive. « Ces découvertes établissent la supplémentation en SGO1 comme une stratégie potentielle pour préserver la cohésion des chromatides dans les ovocytes vieillissants », ont écrit les chercheurs dans leur article, publié la semaine dernière sur le serveur de préimpression bioRxiv.
Et maintenant ? Prudence et perspectives
Bien sûr, il ne faut pas s’emballer trop vite. C’est prometteur, certes, mais la recherche en est encore à ses balbutiements. Les chercheurs prévoient de présenter leurs travaux à la British Fertility Conference à Édimbourg plus tard cette semaine, mais il faut noter que l’étude n’a pas encore passé l’étape cruciale de l’examen par les pairs. C’est le garde-fou indispensable de la science. L’équipe devra également prouver que l’ajout de Shugoshin 1 améliore réellement les résultats de fertilité – c’est-à-dire que cela mène bien à des naissances – et que la procédure peut être réalisée de manière fiable et sûre.
Ils prennent aussi le soin de préciser une limite importante : un tel traitement ne rendrait pas la FIV possible pour les femmes déjà ménopausées. Cela ne remet pas en marche une horloge arrêtée. Mais comme la FIV devient de plus en plus courante chez les femmes plus âgées, cette recherche, si elle tient ses promesses, pourrait rendre ces procédures beaucoup moins aléatoires pour ce groupe.
Güneş Taylor, chercheur en fertilité à l’Université d’Édimbourg, qui n’a pas participé à l’étude, a souligné au Guardian : « C’est un travail vraiment important car nous avons besoin d’approches qui fonctionnent pour les ovules plus âgés, car c’est là que se trouvent la plupart des femmes ». Pour aller plus loin, Melina Schuh et ses collègues ont même fondé l’entreprise Ovo Labs dans l’espoir de développer et de commercialiser leur technique. L’avenir nous dira si cette injection expérimentale deviendra la norme.
Ce contenu a été créé avec l’aide de l’IA.